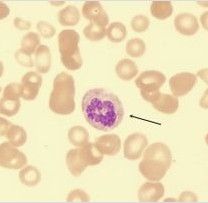
惡性貧血 惡性貧血

疾病簡介
惡性貧血
細胞良性貧血有別於惡性貧血,前者是由於缺鐵,使血紅蛋白(血色素)合成減少,但紅細胞不低;後者是缺乏葉酸和維生素B12等造血因子,使幼稚紅細胞在發育中的脫氧核糖核酸(DNA)合成出現障礙,細胞的分裂受阻,形成畸形的巨幼紅細胞,並伴有神經症狀(神經炎、神經萎縮)。
病因
惡性貧血的基本缺陷是因胃黏膜永久性的萎縮,不能分泌內因子。由於缺乏內因子,食物中的維生素B12不能被吸收。這種胃黏膜萎縮,一般指慢性萎縮性胃炎,範圍廣泛,而在胃的體部最顯著,在胃竇部改變較少。胃黏膜萎縮處有大量淋巴細胞和漿細胞浸潤。組織學切片顯示主細胞和壁細胞幾乎完全消失,常常變成象小腸的上皮細胞。由於這些細胞的萎縮,內因子及鹽酸的分泌均不存在,胃蛋白酶的分泌顯著減少。注射組織胺或胃泌素也不能使胃液中出現鹽酸。尿中尿胃蛋白酶的排泄顯著減少。血液中胃泌素的濃度增高。
惡性貧血的發病機理目前多認為是遺傳因素和自體免疫因素複雜的相互作用的結果。
遺傳因素:惡性貧血的發生與種族和遺傳顯然有關。諸如①本病最多見於北歐的斯堪的那維亞人,特別是瑞典中部的人;②惡性貧血患者血型屬於A型者比其他型者多;③約有10%病人,其同一代或不同代的家族中患有同病者超過1人;在家族中有血清維生素B12濃度低於正常,血清或胃液中有自抗體及患有其他自體免疫疾病的發病數都比一般人高。
自體免疫因素:惡性貧血病人同時患有其他自體免疫疾病,如甲狀腺機能亢進、甲狀腺機能減退及橋本氏甲狀腺炎者較多見。很多患者的血清及胃液中可查出胃的自抗體,如壁細胞抗體,內因子抗體,抗內因子抗體等,這些抗體可直接引起胃黏膜萎縮和維生素B12吸收障礙。
臨床表現
典型病例有下列三組特徵:①巨幼細胞性貧血;
②舌炎與胃酸缺乏;
③周圍神經變性與脊髓聯合變性。神經系統症狀主要有:周圍神經變性引起肢體麻木感或感覺異常;脊髓後索變性引起腱反射消失,肌張力減弱,位置覺紊亂;反射亢進與肌張力增強等。神經系統症狀可為本病的突出表現,甚至病人被疑為周圍神經炎或多發性硬化而首先就診於神經科。
血象出現巨紅細胞,骨髓顯示巨幼紅細胞增生。胃酸缺乏,空腹血清胃泌素顯著增高。有條件可檢測內因子及其抗體。
診斷
本病的診斷一般可根據臨床特徵、血象與骨髓象、胃液分析、維生素B12的療效以及長期隨診而確定。血清維生素B12測定、放射性核素維生素B12吸收試驗也有助診斷。首先應與紅血病相鑑別,後者用維生素B12治療無效,且幼稚紅細胞形態有明顯的病理改變。在再發期病例常有溶血現象,應注意與其他類型溶血性貧血相區別。病人有食慾減退、胃游離鹽酸缺乏,尚需與胃癌相區別;但須注意,本病可為胃癌的前期。
國產維生素B12療效常不顯著,常用彌可保,再者針灸治療能明顯改善下肢無力症狀。
治療
對由營養不良、嬰兒期、妊娠期的惡性貧血患者,可選用葉酸治療,成人1次5~10mg,兒童1次5mg,1日3次,同時輔以維生素B12肌內注射1次0.5~1.5mg,口服每日1.5~4.5mg。對藥物引發的貧血,合併套用甲醯四氫葉酸鈣靜滴治療,1次1mg,1日1次。(1)葉酸:維生素B12缺乏時可以同時伴有葉酸缺乏,故對惡性貧血(或其他原因引起的維生素B12缺乏的巨幼細胞貧血)患者可以同時給以葉酸。但必須注意對維生素B12缺乏的病人單純用葉酸治療而不給以維生素B12是有害的,應予禁止。因為單獨用葉酸治療雖然也能使血象進步,但對神經系統病變有害而無益。單獨用葉酸治療時,由於血液方面的進步消耗了更多的維生素B12,使神經系統組織內維生素B12的缺乏更加嚴重,結果使神經系統的症狀加重或本來沒有而促使其出現,造成嚴重後果。因此,葉酸必須與維生素B12同時套用。
(2)鐵鹽:惡性貧血(或其他原因的維生素B12缺乏)治療後,由於紅細胞和血紅蛋白的大量生成,需用大量鐵,原來潛在的缺鐵便表現出來。此時如給以鐵劑治療可引起第二次網織紅細胞計數的上升,並加速血象完全恢復正常。
(3)輸血:維生素B12治療後,即使本來貧血很嚴重的病人,一般都能迅速改善,故大多數病人不需輸血。如果確有輸血的適應證,最好用濃集的紅細胞而不用全血,以防輸入液太多,引起心力衰竭。輸血速度應緩慢,特別對有心力衰竭或老年病人。惡性貧血用適當的維生素B12治療後,血液方面的預後很好,能完全恢復正常。但由於胃黏膜萎縮和內因子的分泌不能恢復正常,故治療是持續的、終身的,否則貧血仍將復發。神經系統方面的改變,如果已經發生脊髓變性,有下肢癱瘓或括約肌功能紊亂等症狀,很難再恢復正常。患者以後發生胃癌的機會比同齡人要高3倍,特別在男性中。
護理要點
給病人富於營養和高熱量、高蛋白、多維生素、含豐富無機鹽和飲食,以助於恢復造血功能。缺鐵性貧血可多吃動物的內臟,如心、肝、腎以及牛肉、雞蛋黃、大豆、菠菜、紅棗、黑木耳等。
巨幼紅細胞性貧血在療程後期可能出現相對缺鐵現象,要注意及時補充鐵劑。
再生障礙性貧血患者要注意防止交叉感染,儘量不要去公共場所。住房要通風。忌服合黴素、氯黴素、磺胺類、退熱止痛片等抑制骨髓的藥物。
避免過度勞累,保證睡眠時間。